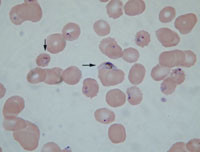
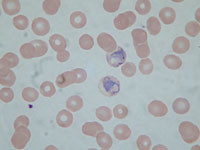
Figur 2   Pasient 1. To am&oslash;boide plasmodium vivax-trofozoitter ved innleggelse p&aring; grunn av residiv
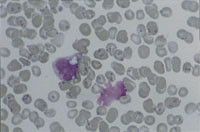
Figur 3   Pasient 2. Erytrocytter infisert med opptil 4 &ndash; 5 P falciparum-trofozoitter, parasittemi p&aring; 40 &ndash; 50 %
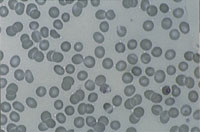
Figur 4   Pasient 2. Reduksjon av parasittemien til ca. 1 % etter utskiftingstransfusjon

Background.
Acute severe malaria can be seen at any Norwegian hospital. The prognosis of this serious disease depends on rapid and effective treatment.
Material and methods.
Two case reports of patients treated with exchange transfusions are presented.
Results.
Two young Norwegian women travelled without adequate prophylaxis against malaria in South-East Asia and Central and Southern Africa respectively. A few days after leaving the endemic areas they got high fever, joint and muscular pain, and headache. In one of the patients the symptoms were interpreted as flu symptoms; one week later the patient was admitted to hospital suffering from severe malaria. The other patient was admitted to hospital on the day she returned to Norway, six days after getting febrile. Thin blood films showed Plasmodium falciparum, with 30 % and 40 – 50 % parasitaemia respectively. Both patients were icteric with thrombocytopenia and increased creatinine. The first patient had severe renal failure and signs of cerebral affection. She was treated with haemodialysis and exchange transfusions. The other patient was treated with exchange transfusions because of her high parasitaemia. Both patients made a complete recovery and were discharged after three and two weeks.
Interpretation.
Severe falciparum malaria is a condition with high case-fatality if diagnostics and treatment is not optimal. In especially severe cases, exchange transfusion may be lifesaving.
Hvert år dør mer enn en million mennesker i verden av falciparummalaria, og de fleste av disse er barn i Afrika sør for Sahara (1). Dødsfall hos reisende fra i-land har vanligvis sammenheng med inadekvat profylakse, diagnostikk eller behandling (2). Det har i det siste årlig vært meldt ca. 80 tilfeller av importert malaria til Meldingssystem for smittsomme sykdommer (MSIS) (3). Tidligere var Plasmodium vivax dominerende, men siden 1992 har Plasmodium falciparum vært den vanligste formen av malaria i Norge (4). I 2000 ble det i MSIS registrert ett dødsfall (3), mens det i perioden 1992 – 99 ikke ble registrert noe dødsfall i Norge pga. malaria (5).
WHO registrerte ca. 37 000 tilfeller av malaria i Europa i 1999, 13 000 tilfeller var importerte, hovedsakelig i Frankrike, Storbritannia, Italia og Tyskland (6). Det ble registrert 680 dødsfall pga. malaria i Europa i perioden 1989 – 99.
Falciparummalaria er en akutt, alvorlig tilstand som krever rask diagnostikk og behandling (7). Viktigheten av dette illustreres med to kasustikker fra pasienter behandlet med utskiftingstransfusjon.
Pasient 1. En 23 år gammel kvinne reiste i 11 måneder i India, Thailand og Indonesia uten adekvat malariaprofylakse. 11.2. 1998 kom hun hjem til Norge. Fem dager senere fikk hun høy feber med frostanfall, hodepine, diare… og etter hvert så godt som ingen vannlating. Tilstanden ble oppfattet som influensa. 22.2. ble hun innlagt ved Aust-Agder sentralsjukehus. Hun var da høyfebril med temperatur 40 ˚C, var urolig og hadde smerter i hele kroppen, men var klar og orientert. Kliniske tegn og blodprøver viste splenomegali, icterus (s-bilirubin 100 µ mol/l), nyresvikt (s-kreatinin 374 µ mol/l), dehydrering og hyponatremi (s-Na 126 mmol/l), anemi (Hb 10 g/100 ml) og hypoglykemi (s-glukose 3 mmol/l). Hun hadde trombocytopeni (trombocytter 25 × 10⁹/l) og forhøyet D-dimer (12 mg/l), men normal NT. Vi fant moderat leukocytose (leukocytter 10,5 × 10⁹/l), og for øvrig kraftig forhøyede infeksjonsparametere (CRP 319 mg/l og SR 74 mm). Leverprøver var moderat forhøyet (ASAT 318 U/l, ALAT 150 U/l og GT 60 U/l).
Plasmodium falciparum ble påvist i tynndråpepreparat, som viste 30 % parasittemi (fig 1) og flere karakteristiske bananformede gametocytter.
Pasienten fikk straks etter innkomst behandling med kinin 600 mg × 3 og samtidig glukose intravenøst. Neste dag ble hun mentalt påvirket, og nyresvikten ble forverret. Tynndråpepreparat viste uendret parasittemi. Det ble gjort hemodialyse. I løpet av dagen ble hun somnolent, og 23.2. ble hun overflyttet til Ullevål universitetssykehus. Det ble der gjort blodutskifting av 2,4 l blod. Vi fortsatte med kinin intravenøst og gav i tillegg doksycyklin. 26.2. kunne vi ikke lenger påvise parasitter i tynndråpepreparat. Intravenøs behandling kunne avsluttes til fordel for peroral behandling med meflokin og doksycyklin. 2.3. ble pasienten flyttet tilbake til Aust-Agder sentralsjukehus. 13.3. var hun ikke lenger dialysetrengende. 18.3. kunne hun utskrives i god allmenntilstand, tilsynelatende uten tegn til nevrologisk sekvele.
30.4. ble pasienten innlagt på ny pga. feber. Tynndråpepreparat viste infeksjon med P vivax (fig 2). Dobbeltinfeksjon forelå sannsynligvis ved første innleggelse, men diagnosen ble den gang ikke stilt, og leverstadiet av vivaxparasitten var derfor ikke behandlet. Hun fikk nå behandling med klorokin og primakin, og var da ferdigbehandlet for sin malaria.

Praktisk håndtering av utskiftingstransfusjonene
Pasient 1 ble tappet for i alt åtte enheter på 300 ml blod fra dialysekateter i lysken i løpet av ti timer. Blodet ble erstattet med sju enheter SAG-blod (7 × 300 ml) og to enheter plasma (2 × 200 ml). I tillegg fikk hun to enheter trombocytter for å redusere blødningsrisikoen. Infusjon og tapping ble utført avvekslende gjennom hvert sitt løp i dialysekateteret. De første fire blodtappingene ble utført i løpet av tre timer, resten med større intervall.
Hos pasient 2 ble blod tappet fra arteriekran og erstattet gjennom en stor perifer kanyle. Det ble utskiftet et volum svarende til 4,5 l fullblod i løpet av 15 timer. Det var ingen anemi, og vi erstattet derfor kun det uttappede volum. Hun fikk to enheter trombocytter før utskiftingstransfusjonen ble startet. Blodet ble kontinuerlig gitt i form av først tre enheter SAG-blod og deretter ni enheter nytappet fullblod. En enhet SAG-blod eller fullblod ble infundert i løpet av en time. I samme tidsrom ble tilsvarende blodvolum tappet ut via arteriekranen, ved at 80 – 100 ml ble tappet ut hvert 15. minutt. For å unngå forverring av trombocyttopenien ble det to ganger mellom blodtransfusjonene gitt to enheter trombocyttkonsentrat.
Diskusjon
Alvorlig malaria
Mer enn 2 % parasittemi med P falciparum hos ikke-immune eller gravide, og mer enn 5 % parasittemi hos semiimmune, gir risiko for utvikling av multiorgansvikt og cerebral malaria i løpet av timer eller dager (8, 9). En retrospektiv undersøkelse av barn med malaria i Gambia viste gjennomsnittsvarighet mellom symptomdebut og død på 2,8 dager (10). Prognosen er derfor avhengig av rask og effektiv behandling.
Kliniske symptomer
Falciparummalaria hos en ikke-immun gir ofte initialt langtrukne feberepisoder, uten det samme klassiske mønster som ved de benigne malariaformer (8, 11).
Øvrige tidlige symptomer inkluderer hodepine, slapphet, artralgi, myalgi eller ryggsmerter, kvalme, oppkast, magesmerter og diaré (8, 9). Ukomplisert malaria kan raskt utvikle seg til en livstruende tilstand med komplikasjoner i form av cerebral malaria (definert som koma i mer enn seks timer) (7), kramper, nyresvikt, lungeødem, sjokklunge (adult respiratory distress syndrome, ARDS), hemoglobinuri (black water fever), hypoglykemi, laktacidemi, alvorlig anemi, disseminert intravaskulær koagulasjon (DIC) og icterus. To enkle kliniske funn som indikerer alvorlig prognose, er endret bevissthet og respirasjonspåvirkning som tegn på laktacidemi. Bakterielle superinfeksjoner i form av sepsis, aspirasjonspneumoni eller pyelonefritt er ikke uvanlig.
Patogenese ved multiorgansvikt ved alvorlig malaria
Patogenesen ved alvorlig malaria og cerebral malaria er ikke avklart. Det er kjent at parasittinfiserte erytrocytter adhererer til endotel, og at de også binder til seg normale røde blodceller (8). En hypotese går ut på at dette gir mikrovaskulær obstruksjon og iskemi i vitale organer som hjerne, placenta, nyrer, tarm o.a., med anaerob glykolyse og hypoglykemi og laktacidemi som resultat (12, 13). Ut fra denne mekaniske hypotesen er koma ved cerebral malaria en følge av iskemi.
Cytokinteorien bygger på at koma ved cerebral malaria skyldes at infiserte erytrocytter som har klebet seg fast i mikrosirkulasjonen i hjernen, gir en lokalt høy produksjon av parasittoksiner som induserer cytokinproduksjon, spesielt tumornekrosefaktor (TNF) (12, 13). Denne stimulerer til danning av nitrogenoksid, som gir koma. Laktacidemi og hypoglykemi ved alvorlig malaria er ut fra denne teorien uttrykk for cytokiners hypermetabole funksjoner, og ikke resultat av iskemi og anaerob glykolyse. Bare 5 – 10 % av pasienter med cerebral malaria som overlever får nevrologisk sekvele, og CT eller MR er normale i de fleste tilfeller, noe som ikke er forenlig med forandringene man ville forvente ved langvarig coma pga. iskemi (13).
Behandling
Ved alvorlig malaria anbefales behandling med kinin langsomt intravenøst, eventuelt med tillegg av et parenteralt tetrasyklin. Alternativt kan det brukes et artemisininderivat (artemether eller artesunate), som synes like effektivt og har få bivirkninger (9, 11, 14). Artemisininbehandling bør også kombineres med enten meflokin eller doksycyklin. Samtidig infusjon med glukose er viktig pga. risikoen for hypoglykemi, som også kan forsterkes av kininbehandling. Artemisininderivater og kinin er ikke registrerte preparater (11). Artemisininpreparater finnes i beredskap ved noen større sykehus, men alle norske sykehus må ha kinin injeksjonsvæske tilgjengelig.
Bruk av utskiftingstransfusjon ved alvorlig malaria
Flere rapporter viser et svært raskt fall i antall parasitter i blodet ved utskiftingstransfusjon (15). Vi vet at prognosen forverres ved høy parasittemi, og utskiftingstransfusjon for å redusere parasittemien synes derfor logisk. Det finnes ingen randomiserte kontrollerte kliniske forsøk som dokumenterer nytten av utskiftingstransfusjon, men flere kasuistiske meddelelser rapporterer om gunstig klinisk effekt (15, 16). Samtidig er det lite trolig at eventuell mislykket bruk av transfusjon blir publisert. Bruk av utskiftingstransfusjon må derfor vurderes på teoretisk grunnlag.
Vår pasient 1 hadde allerede utviklet organkomplikasjoner, noe som i tillegg til en parasittemi på 30 % gav indikasjon for utskiftingstransfusjon. Hos pasient 2 var indikasjonen den meget høygradige parasittemien alene (40 – 50 %). Hos begge pasientene fikk vi en rask reduksjon i parasittemien, hvilket vi tror var vesentlig for det gunstige forløp.
Utskiftingstransfusjon kan utføres på to måter: Man kan via perifere tilganger tappe ut og infundere blod, eller man kan utføre maskinell erytrocyttaferese, hvor man bare skifter ut erytrocyttene. Ved den første metoden fjerner man og må erstatte plasma og eventuelt andre celler som trombocytter, mens man ved aferese beholder plasma. Fordelen med den maskinelle metoden er at man langt raskere kan skifte ut erytrocyttene.
Hva som er viktigst å fjerne ved alvorlig malaria er usikkert. Det er viktig å fjerne infiserte erytrocytter, men samtidig er det i plasma en rekke betennelsesmediatorer og toksiner som må antas å ha betydning for sykdomsbilde og multiorganaffeksjon ved alvorlig malaria. Det vil derfor teoretisk også være gunstig å fjerne disse. Gunstig effekt av plasmaferese ved malaria er også rapportert (17). På den annen side vil tap av viktige proteiner, som for eksempel koagulasjonsfaktorer, være ugunstig. Ved blodutskifting får man heller ikke fjernet de modne formene av P falciparum, da disse finnes i erytrocytter som er klebet fast i mikrosirkulasjonen.
Hvor stort volum som bør skiftes ut er usikkert. Ved fullblodsutskifting varierer volumet i publiserte studier i størrelsesorden 1 – 12 l, men hovedtyngden ligger på et volum rundt 4 – 5 l over 10 – 15 timer.
Hemodynamisk instabilitet og hypersensitivitetsreaksjoner vil kunne forekomme. Risiko for overføring av smittestoffer, spesielt ved bruk av fersktappet fullblod, foreligger også. Andre komplikasjoner som er beskrevet er elektrolyttforstyrrelser og intracerebral blødning (18).
Autoriteter på området anbefaler utskiftingstransfusjon ved mer enn 15 – 30 % parasittemi og vurdering av det samme ved parasittemi over 5 % dersom alvorlige organkomplikasjoner foreligger (19, 20). Det anbefales primært utskifting av et volum svarende til 4 – 5 l fullblod. Hvorvidt man velger manuell blodutskifting eller erytrocyttaferese, vil avhenge av erfaring og ekspertise ved det enkelte sykehus.
Konklusjon
Sykehistoriene viser at forsinket behandling av falciparummalaria raskt kan føre til en livstruende tilstand. Alvorlig malaria kjennetegnes ved mikrovaskulær obstruksjon og toksinfrisetting fra parasitter. Dette gir affeksjon av vitale organer, bl.a hjerne, tarm og nyrer. I tillegg til nødvendigheten av rask diagnostikk er det viktig at sykehusene har tilgjengelig de nødvendige medikamenter ved klorokinresistent P falciparum: kinin og ev. artemisinin. Blodutskifting kan være nødvendig og livreddende behandling.
- 1.
The world health report 1999. Genève: WHO, 1999: 49 – 63.
- 2.
Centers for Disease Control and Prevention. Malaria deaths following inappropriate malaria chemoprophylaxis – United States, 2001. MMWR Morb Mortal Wkly Rep 2001; 50: 597 – 9.
- 3.
Blystad H, Løvoll Ø. Malaria i Norge 2000. MSIS rapport 2001; 29: 15.
- 4.
Blystad H, Iversen BG, Lystad A. Malaria-insidens av import til Norge. MSIS rapport 1997; 25: 3.
- 5.
Blystad H. Import av malaria til Norge 1989 – 98 Tidsskr Nor Lægeforen 2000; 120: 1653 – 7.
- 6.
Sabatinelli G, Ejov M, Joergensen P. Malaria in the WHO European Region (1971 – 1999). Eur Surveill 2001; 6: 61 – 5.
- 7.
World Health Organisation. Severe falciparum malaria. Trans R Soc Trop Med Hyg 2000; 94 (suppl 1): 1 – 90.
- 8.
Krogstad DJ. Plasmodium species (Malaria). I: Mandel GL, Bennett JE, Dolin R, red. Principles and practice of infectious diseases. 5. utg. Philadelphia: Churchill Livingstone, 2000: 2817 – 31.
- 9.
Stanley J. Malaria. Emerg Med Clin of North Am 1997; 15: 113 – 55.
- 10.
Greenwood BM, Bradley AK, Greenwood AM, Byass P, Jammeh K, Marsh K et al. Mortality and morbidity from malaria among children in rural area of the Gambia, West Africa. Trans R Soc Trop Med Hyg 1987; 81: 478 – 86.
- 11.
Myrvang B. Malaria i Norge – diagnostikk, behandling og profylakse Tidsskr Nor Lægeforen 2000; 120: 1648 – 52.
- 12.
Warrell DA. The 1996 Runme Shaw Memorial Lecture: malaria – past, present and future. Ann Acad Med Singapore 1997; 26: 380 – 7.
- 13.
Clark IA, Al Yaman FM, Jacoboson L. The biological basis of malarial disease. Int J Parasitol 1997; 27: 1237 – 49.
- 14.
Gundersen SG. Malaria. I: Vennerød AM, red. Norsk legemiddelhåndbok for helsepersonell 2001. Oslo: Foreningen for utgivelse av Norsk legemiddelhåndbok, 2001: 81 – 5.
- 15.
Phillips P, Nantel S, Benny WB. Exchange transfusion as an adjunct to the treatment of severe falciparum malaria: case report and review. Rev Infect Dis 1990; 12: 1100 – 7.
- 16.
Strand EA, Strand ØA, Hellum KB, Smith-Erichsen N, Myrvang B. En ung stuporøs, afebril mann med icterus og neseblødning Tidsskr Nor Lægeforen 2002; 122: 619 – 23.
- 17.
White NJ. What is the future of exchange transfusions in severe malaria? J Infect 1999; 39: 185 – 6.
- 18.
Pasvol G, Jacobs M. What is the future of exchange transfusion for falciparum malaria? J Infect 1999; 39: 183 – 4.
- 19.
White NJ. The treatment of malaria. N Engl J Med 1996; 335: 800 – 6.
- 20.
Ekvall H, Aust-Kettis A, Bjørkman A. Svår falciparummalaria hos thailandsresenär. Läkartidningen 1997; 94: 1713 – 5.